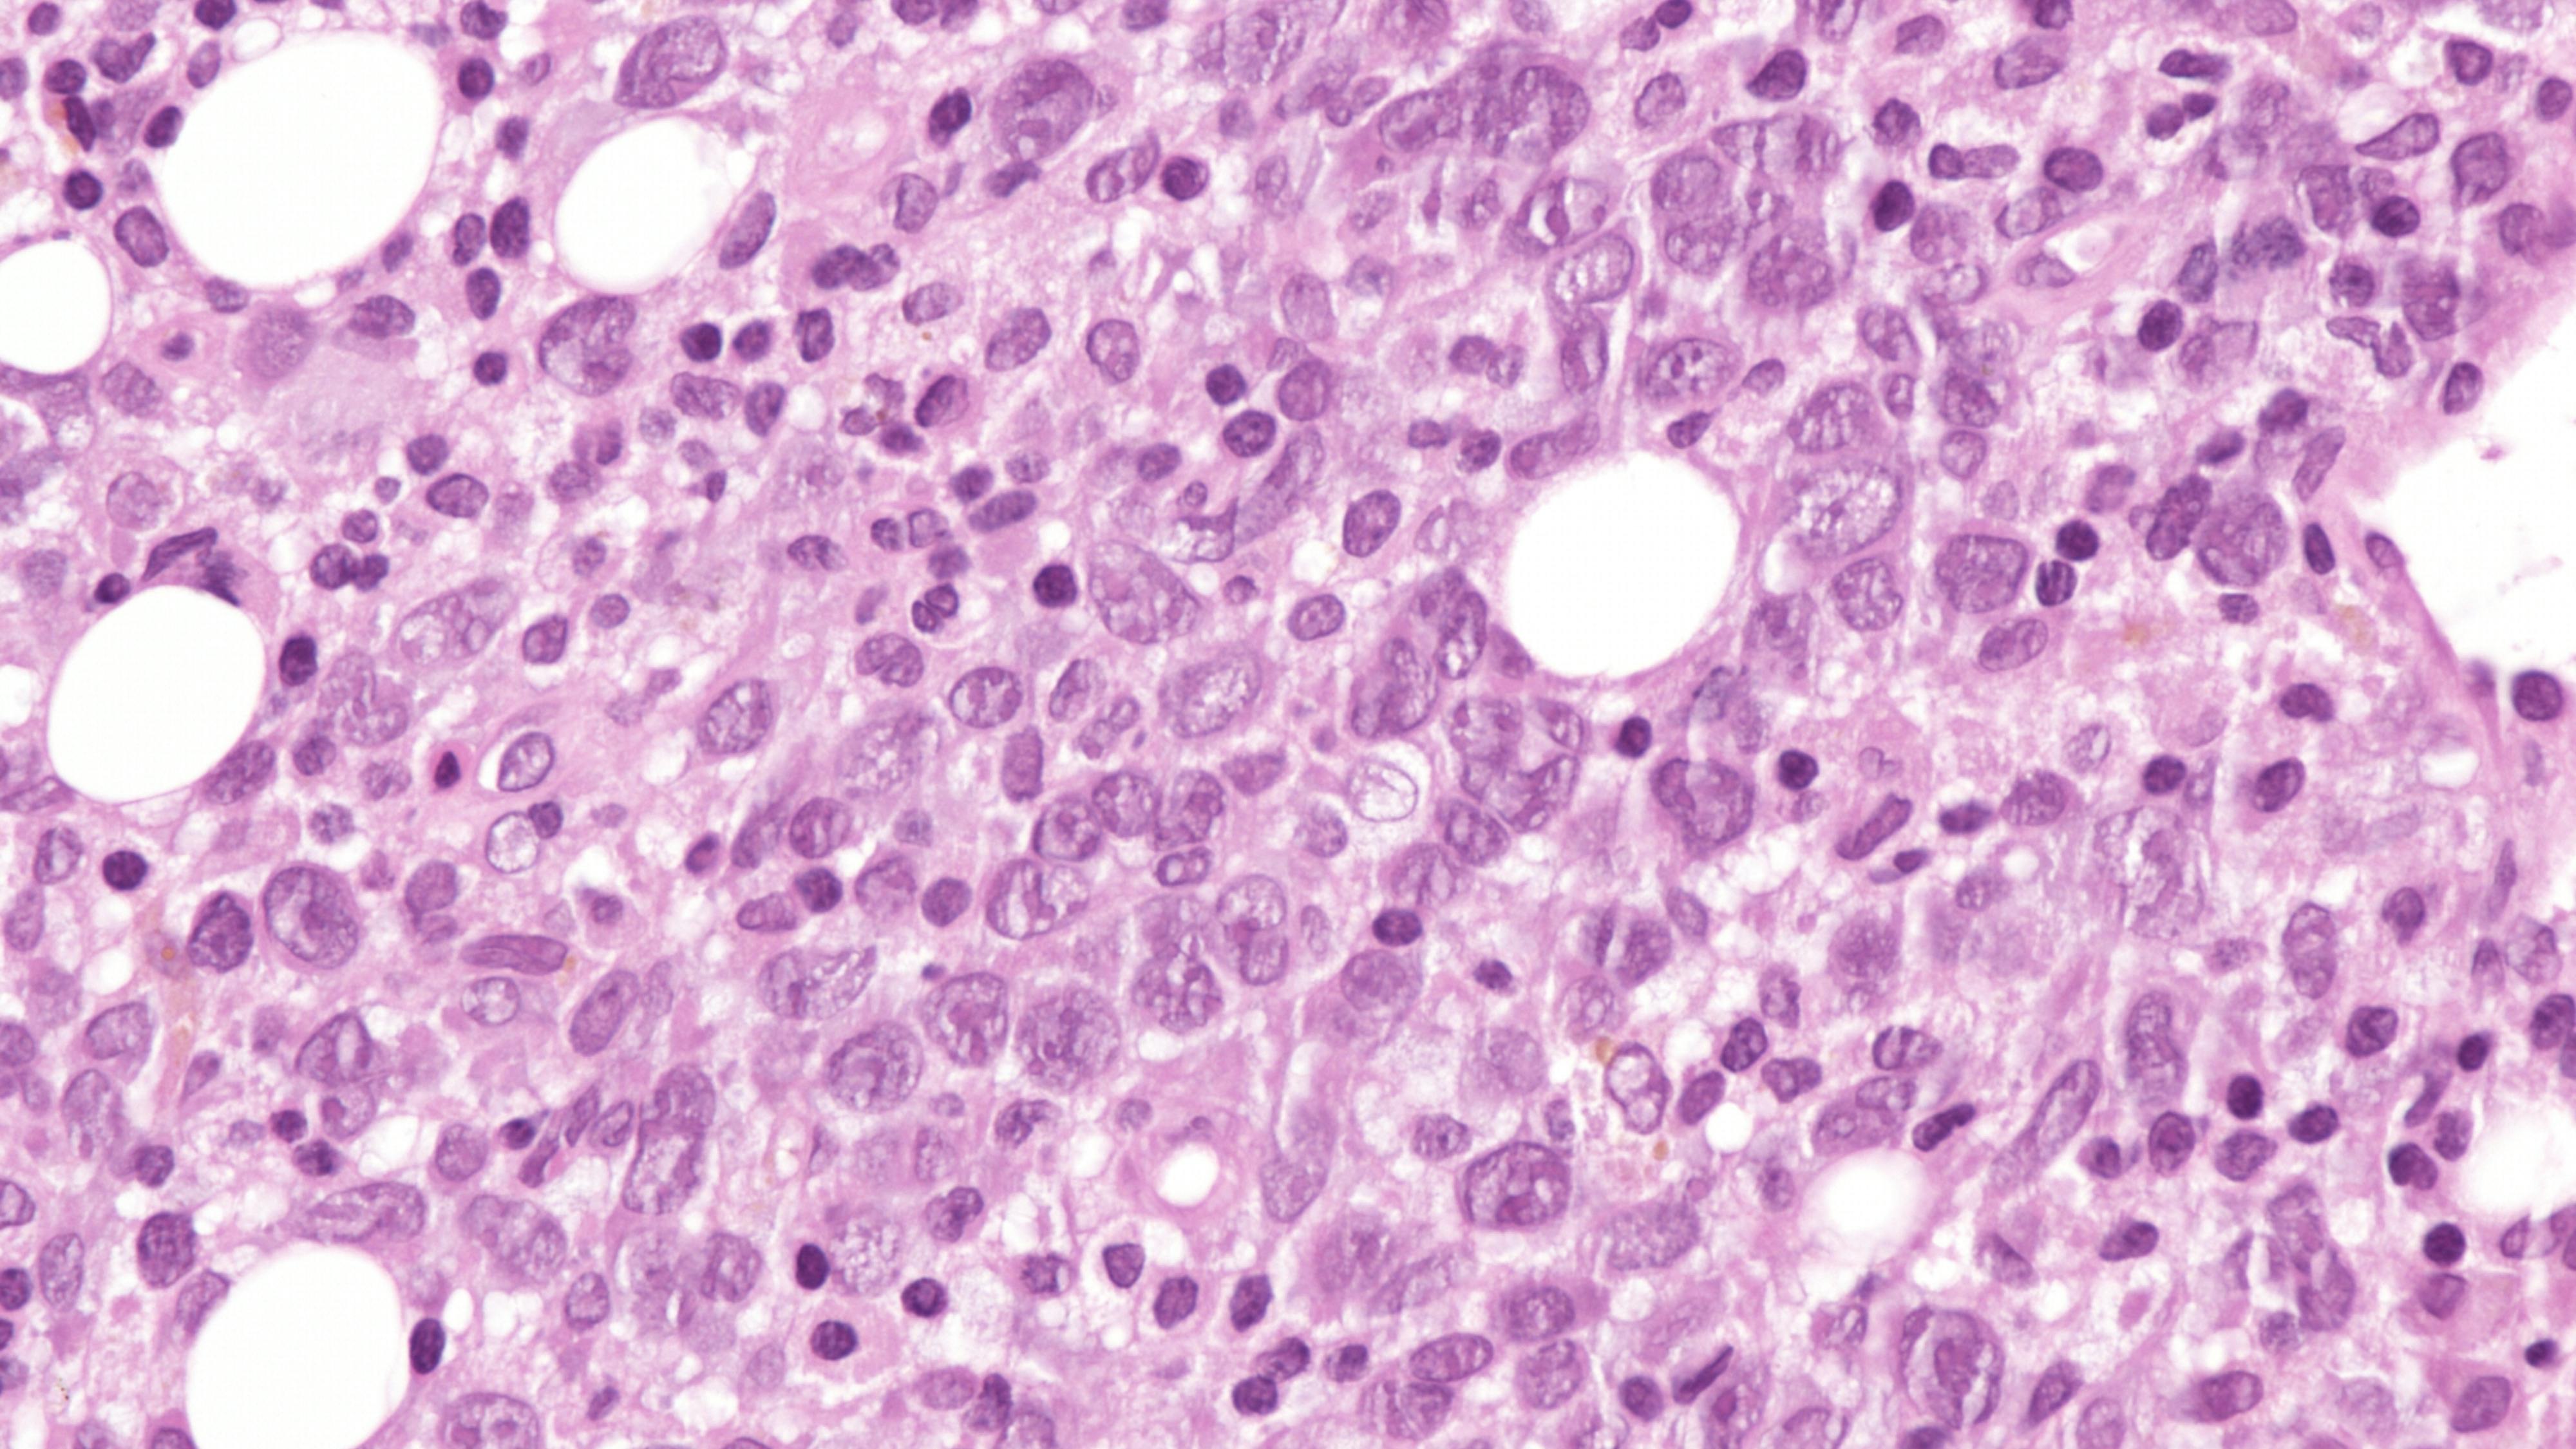
6786848cdcaecd8d5a3ecc52 Dreamstime Xxl 342822543

Roche receives FDA clearance for new, highly sensitive test to aid clinicians in diagnosing B-cell lymphoma
Roche announced that it has received 510(k) clearance from the United States Food and Drug Administration (FDA) for its highly sensitive, in-situ hybridization (ISH) test, the VENTANA Kappa and Lambda Dual ISH mRNA Probe Cocktail.
The test is designed to help pathologists differentiate a B-cell malignancy from a normal, reactive response to an infection. This announcement follows the assay's CE Mark approval in Europe in June 2024.
With increased sensitivity, the new VENTANA Kappa and Lambda Dual ISH mRNA Probe Cocktail enables assessment across the more than 60 B-cell lymphoma subtypes and plasma cell neoplasms on a single tissue slide. The test can assess small biopsies and formalin-fixed tissue, reducing the need for a fresh tissue sample, which may not be available especially if lymphoma was not originally suspected. These test properties preserve tissue, may result in fewer additional patient biopsies and make interpretation quicker and easier for the pathologist, helping facilitate a faster diagnosis and access to treatment for patients.